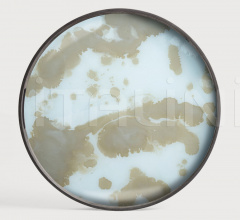
Поднос Mist Gold Organic glass tray Поднос Mist Gold Organic glass tray фабрика Ethnicraft

Почему покупают у нас мебель и предметы интерьера фабрики Ethnicraft (Этникрафт):
Наши цены являются оптимально низкими, на 20-25 % ниже
чем у конкурентов.
Доставка в любой город России и странам СНГ (Казахстан,
Белоруссия, Азербайджан и др).
Поставки мебели под ключ, от размещении на фабрике до
установки сборки на объекте.
Уютный шоу рум в Москве с мебелью в наличии.
Поставки любой мебели и предметов интерьера с лучших
фабрик Италии.
Ниже предоставлен самый полный каталог фабрики Ethnicraft, узнать цены и другие подробности на конкретные позиции можно по телефону : 8 (499) 553-00-18 в Москве или info@italini.ru. Также вы можете задать вопрос ниже, мы свяжемся с Вами в течении нескольких часов в рабочее время.
- Кухонная посуда Ethnicraft
-
Размер (ДхШхВ): 38x38x4 арт.20919
-
Размер (ДхШхВ): 38x38x4 арт.20918
-
Размер (ДхШхВ): 51x51x4 арт.20920
-
Размер (ДхВ): 61x4 арт.20912
-
Размер (ДхВ): 48x4 арт.20418
-
Размер (ДхВ): 61x4 арт.20936
-
Размер (ДхШхВ): 69x31x5 арт.20356 Еще
(ДхШхВ): 51x51x4 арт.20562
(ДхШхВ): 38x38x4 арт.20561
(ДхШхВ): 71x36x2.5 арт.20560
(ДхВ): 92x4 арт.20331
-
Размер (ДхВ): 48x4 арт.20932
-
Размер (ДхВ): 92x4 арт.20462 Еще
(ДхШхВ): 71x36x2.5 арт.20580
-
Размер (ДхВ): 48x4 арт.20450
-
Размер (ДхВ): 48x4 арт.20437
-
Размер (ДхВ): 61x4 арт.20407
-
Размер (ДхШхВ): 69x31x5 арт.20366
-
Размер (ДхВ): 61x4 арт.20374
-
Размер (ДхВ): 61x4 арт.20310
-
Размер (ДхВ): 92x4 арт.20937
-
Размер (ДхШхВ): 69x31x4.5 арт.20465 Еще
(ДхВ): 61x4 арт.20461
-
Размер (ДхВ): 48x4 арт.20459
-
Размер (ДхШхВ): 69x31x4.5 арт.20442
-
Размер (ДхВ): 61x4 арт.20440
-
Размер (ДхВ): 48x4 арт.20438
-
Размер (ДхВ): 48x4 арт.20438 Еще
(ДхШхВ): 71x36x2.5 арт.20543
-
Размер (ДхШхВ): 69x31x4.5 арт.20430
-
Размер (ДхШхВ): 48x x4 арт.20402
-
Размер (ДхШхВ): 92x x4 арт.20449
-
Размер (ДхШхВ): 61x x4 арт.20374
-
Размер (ДхШхВ): 48x x4 арт.20371
-
Размер (ДхШхВ): 48x x4 арт.20366
-
Размер (ДхШхВ): 48x x4 арт.20360
-
Размер (ДхШхВ): 61x x4 арт.20436
-
Размер (ДхШхВ): 61x x4 арт.20336
-
Размер (ДхШхВ): 48x x4 арт.20335
-
Размер (ДхШхВ): 92x x4 арт.20379
-
Размер (ДхВ): 48x4 арт.20301 Еще
(ДхШхВ): 38x38x4 арт.20570
(ДхШхВ): 51x51x4 арт.20571
-
Размер (ДхВ): 92x4 арт.20378 Еще
(ДхВ): 48x4 арт.20305
Задать вопрос по продукции фабрики Ethnicraft
Наш консультант позвонит
вам и проконсультирует
по всем вопросам!